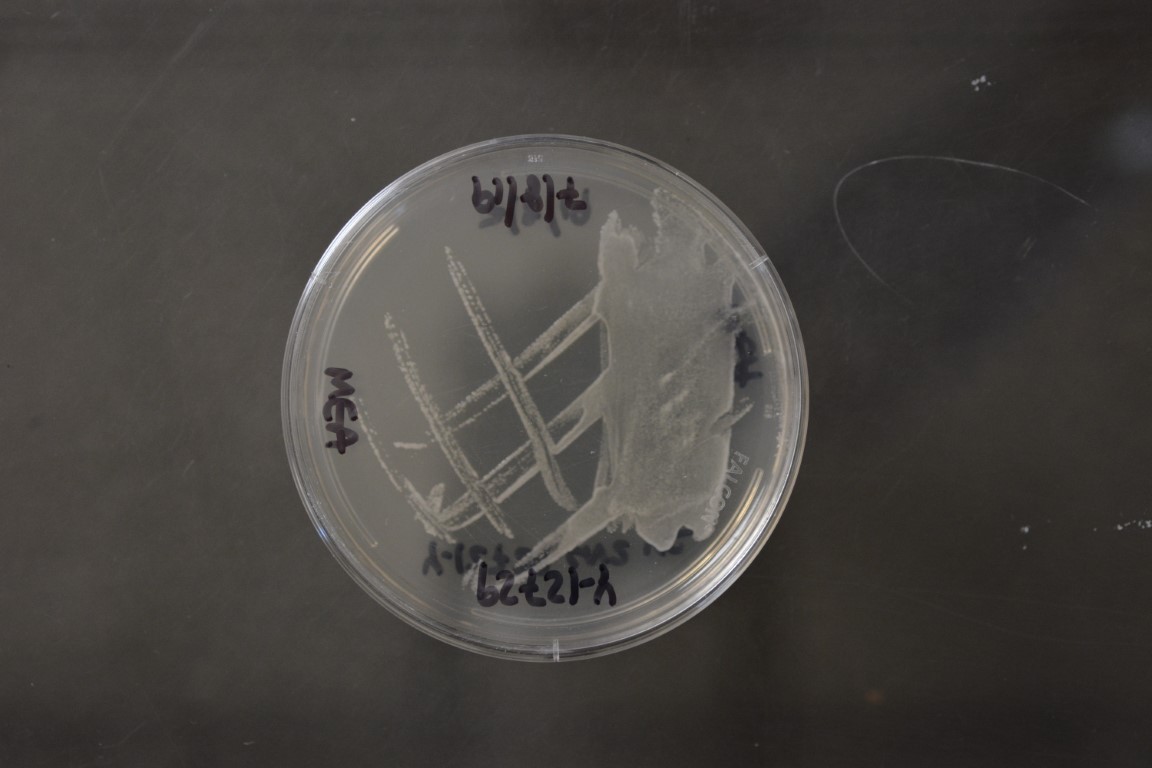

Komagataella phaffii
NRRL Y-12729
Accession numbers in other collections:IMP Y-031880
Source:Etienne,IMP,Mexico
Isolated from(substrate):unknown
Genetic info:Robnett PCR#903;0 diff.D1/D2 with Y-17741,YB-4289,and YB-4290;1 diff.D1/D2 with Y-7556
Growth media:Yeast Extract-Malt Extract-Peptone-Glucose(YM for yeasts)(number 6)
Optimum growth temperature:25C
Strain images:
NRRL_Y-12729_5.JPG